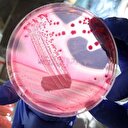

Kök hücre tedavisi doğal ve olumlu bir tedavi yöntemidir.
Kök hücre tedavisi kanserden saç dökülmesine kadar pek çok alanda insanlara farklı umutlar veriyor. Kök hücre tedavisi kireçlenme, eklem sorunları, MS, kıkırdak dejenerasyonu, Burger hastalığı, kalp ve damar hastalıkları, gençleştirici uygulamalar gibi alanlarda kullanılıyor. İşte kök hücre tedavisi hakkında detaylar...
Plastik, Estetik ve Rekonstrüktif Cerrahi Uzmanı Op. Dr. Burak Türkyılmaz, kök hücre tedavisi hakkında önemli açıklamalarda bulundu.
Kök hücre tedavisinin kanserden saç dökülmesine kadar pek çok alanda insanlara farklı umutlar verdiğini dile getiren Plastik, Estetik ve Rekonstrüktif Cerrahi Uzmanı Op. Dr. Burak Türkyılmaz, kök hücre tedavisi hakkında önemli açıklamalarda bulundu.
Kök hücre tedavisinin doğal ve olumlu bir tedavi yöntemi olduğuna değinen Op. Dr. Burak Türkyılmaz, "Kök hücre tedavisi oldukça dikkat çekerken, bu alanda yapılan araştırmaların artması da gelişime katkı sağlıyor. Kök hücreler insan vücudunda bulunan ancak bir organ ya da doku haline gelmemiş hücre gruplarının adı olup, insan vücudunun her noktasında bu hücrelere rastlamak mümkündür” dedi.
Kök hücre hangi tedavi yöntemlerinde kullanılır?
Kök hücre hangi tedavi yöntemlerinde kullanılır?
Op. Dr. Türkyılmaz, kök hücre tedavisinin 1960’lı yıllardan beri uygulandığını, ancak tedavinin ve laboratuvar sürecinin zorluğunun bu tedavinin çok maliyetli olmasına ve uzun yıllar gelişmemesine neden olduğunu dile getirdi.
Kök hücre tedavilerinin kendi içinde farklı şekillerde uygulandığını ifade eden Op. Dr. Türkyılmaz, "Stromal vasküler fraksiyon adı verilen bir sıvı kök hücreden elde edilir ve tedavi bu sıvının transferi ve uyandırılarak dokulara verilmesidir. Bazı tedavilerde göbek bölgesinden yağ alınır ve santrifüj ile bu yağdan çıkarılan madde de kök hücre olarak ifade edilir. Etkili bir kök hücre tedavisi için kök hücrenin kana verilebilmesi gerekir" diye konuştu.
Zararlı yan etkisi var mı?
Zararlı yan etkisi var mı?
Kök hücrelerin belirli doku hücrelerine dönüşebilen öncü hücreler olduğunu sözlerine ekleyen Op. Dr. Türkyılmaz, "Kök hücreler enjekte edildikleri bölgeye göre davranır, yüksek çoğalma kapasitesine ve hücre yenileme potansiyeline sahiptirler ve tıbbın birçok farklı alanlarında kullanıldığı gibi günümüzde estetik cerrahide de geniş bir endikasyon alanı teşkil ederler" dedi.
Dejenerasyona uğramış dokuların yenilenme sürecinde görev alan kök hücreler ile yapılan tedavilerde herhangi bir yan etkiye rastlanılmadığını belirten Op. Dr. Türkyılmaz, yapılan bilimsel çalışmalarda da kök hücre tedavisinin kişiye özel olarak hazırlanması, yani kişinin kendi vücudundan alınan hücreler ile yapılması nedeniyle zararlı bir etkisinin görülmediğini açıkladı.
Kök hücre tedavisinin kireçlenme, eklem sorunları, MS, kıkırdak dejenerasyonu, Burger hastalığı, kalp ve damar hastalıkları, gençleştirici uygulamalar gibi alanlarda kullanıldığını ifade eden Op. Dr. Türkyılmaz, "Kök hücre tedavisi ülkemizde ilk olarak kemik iliği nakli olarak anılmıştır. Lösemi hastalarının tedavisinde kullanılan ve olumlu sonuçları bilimsel olarak kabul edilen bu tedavi yöntemi günümüzde artık sağlık alanındaki gelişmeler sayesinde çok farklı alanlarda umut olmaktadır" şeklinde konuştu.
#Kök hücre
#Kök hücre tedavisi